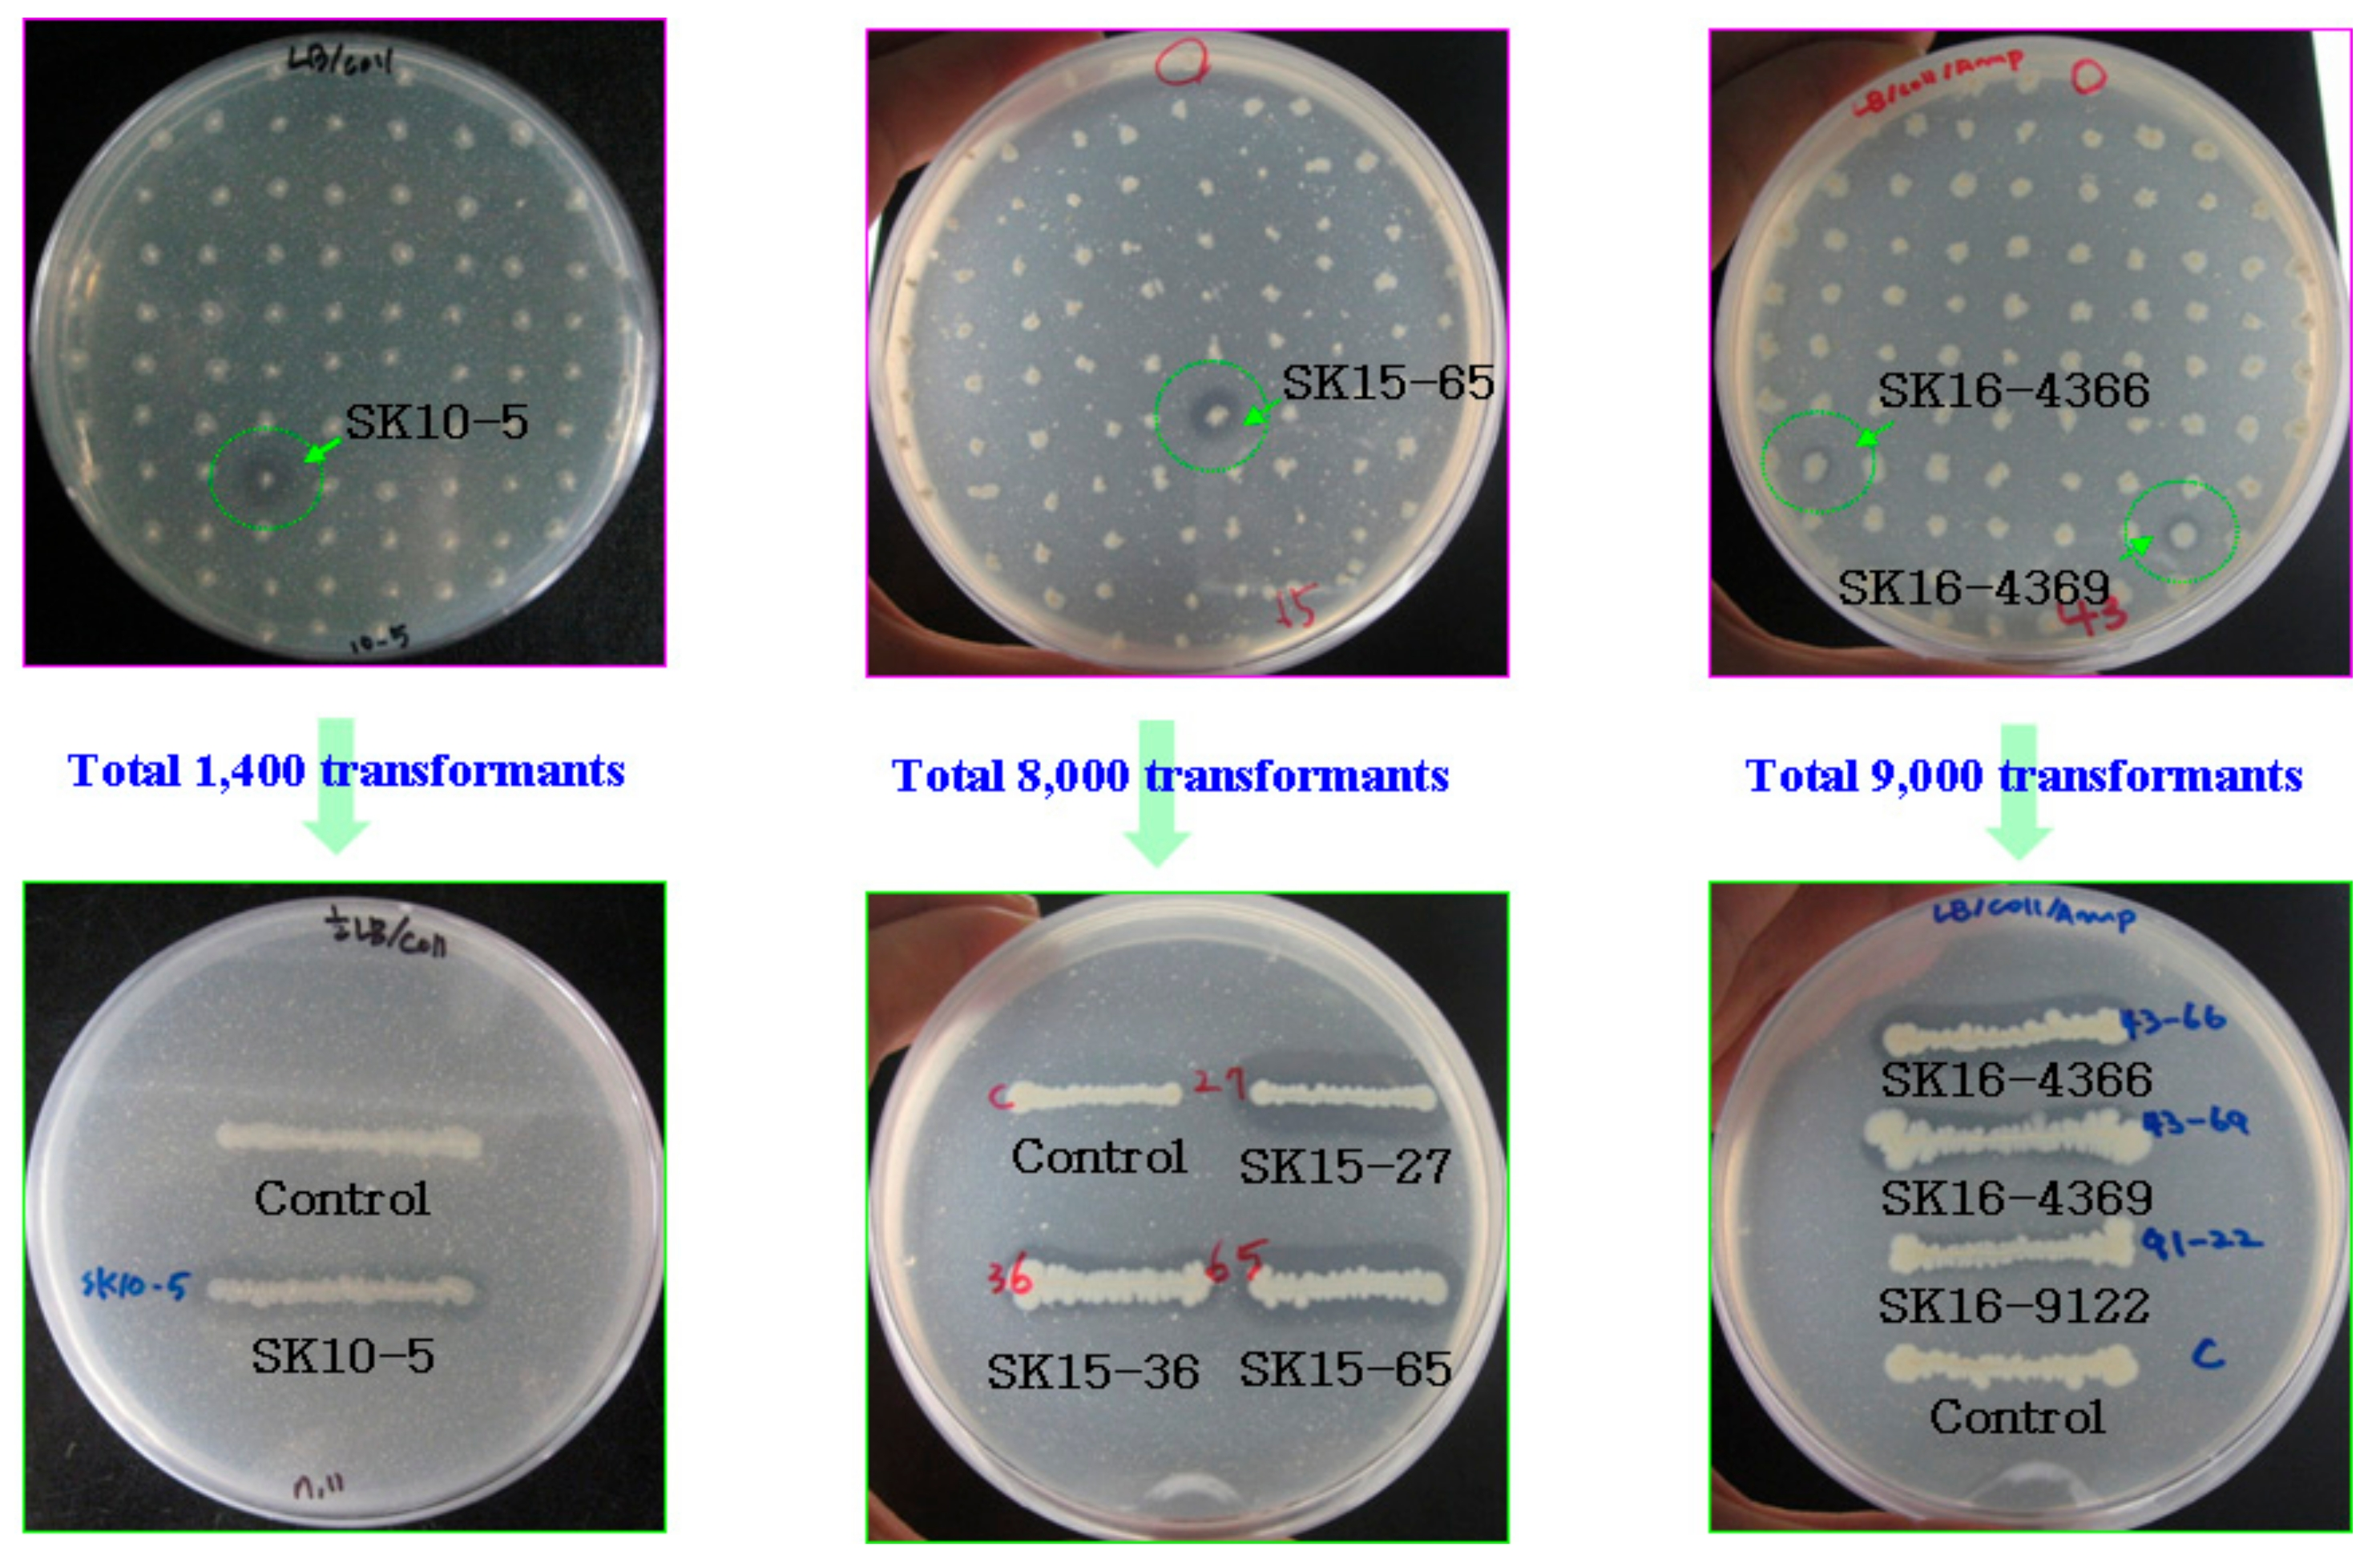
Ijms 22 12822 g003
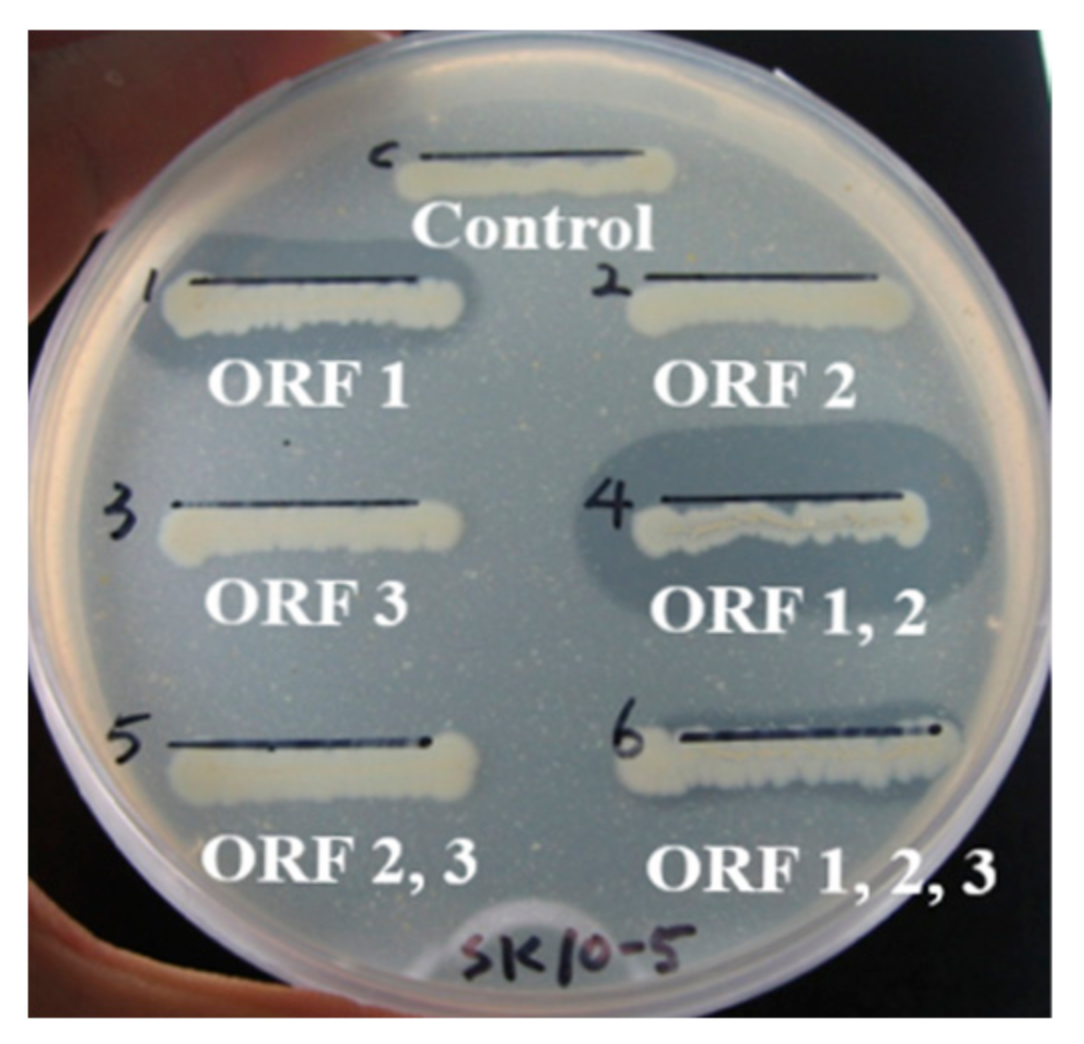
Ijms 22 12822 g006

Molecular Characterization of Four Alkaline Chitinases from Three Chitinolytic Bacteria Isolated from a Mudflat
Abstract
:1. Introduction
2. Results
2.1. Isolation of Chitinolytic Bacteria
2.2. Growth and Chitinase Production from the Isolates SK10, SK15, and SK16
2.3. Growth and Chitinase Production of the Isolates SK10, SK15, and SK16
2.3.1. Cloning of Chitinases from SK10
2.3.2. Subcloning of Chi18A, Chi19B, and Pro2K from SK10-5
2.3.3. Cloning of Chitinase from SK15
2.3.4. Cloning of Chitinase from SK16
2.4. Biochemical Properties of Chitinases in Crude Extracts
2.4.1. Chi18A
2.4.2. Chi19B
2.4.3. Chi18C
2.4.4. Chi18D
2.5. Site-Directed Mutagenesis of Chitinases
2.6. Analysis of the Molecular Masses of Chitinases Using Activity Staining
2.7. Purification of Chi18C and Chi18D
2.8. Properties of the Purified Chi18C and Chi18D
2.9. Hydrolysis of Chitooligosaccharides by the Purified Chi18C and Chi18D
3. Discussion
4. Materials and Methods
4.1. Chemicals
4.2. Isolation of Chitinolytic Bacterial Strains and Culture Conditions
4.3. Identification of Bacterial Strains
4.4. Monitoring the Growth and Chitinolytic Activities of the Isolates SK10, SK15, and SK16
4.5. Cloning and Analysis of Chitinase Genes from the Isolates SK10, SK15, and SK16
4.6. Subcloning of Chitinase Genes from the Active Clone SK10-5
4.7. Enzyme Assay
4.8. Biochemical Characterization of Chitinases
4.9. Estimation of the Molecular Mass of the Chitinases by Activity Staining
4.10. Site-Directed Mutagenesis
4.11. Expression and Purification of Two Chitinases from SK-15 and SK-16 Clones
4.12. Hydrolysis of Chitooligosaccharides and Colloidal Chitin by Purified Chitinases
5. Conclusions
Supplementary Materials
Author Contributions
Funding
Institutional Review Board Statement
Informed Consent Statement
Data Availability Statement
Conflicts of Interest
References
- Muzzarelli, R.A. Chitin; Pergamon Press: Oxford, UK, 1977; ISBN 978-1-4831-5946-1. [Google Scholar]
- Beygmoradi, A.; Homaei, A.; Hemmati, R.; Santos-Moriano, P.; Hormigo, D.; Fernández-Lucas, J. Marine chitinolytic enzymes, a biotechnological treasure hidden in the ocean? Appl. Microbiol. Biotechnol. 2018, 102, 9937–9948. [Google Scholar] [CrossRef] [PubMed]
- Henrissat, B. A classification of glycosyl hydrolases based on amino acid sequence similarities. Biochem. J. 1991, 280 Pt 2, 309–316. [Google Scholar] [CrossRef] [PubMed]
- Sharma, S.; Singh, R.; Kaur, R. In silico characterization of a unique plant-like “loopful” GH19 chitinase from newly isolated Chitinophaga sp. YS-16. Curr. Microbiol. 2020, 77, 2248–2257. [Google Scholar] [CrossRef] [PubMed]
- Wang, X.; Isbrandt, T.; Strube, M.L.; Paulsen, S.S.; Nielsen, M.W.; Buijs, Y.; Schoof, E.M.; Larsen, T.O.; Gram, L.; Zhang, S.D. Chitin degradation machinery and secondary metabolite profiles in the marine bacterium Pseudoalteromonas rubra S4059. Mar. Drugs 2021, 19, 108. [Google Scholar] [CrossRef] [PubMed]
- Lv, C.; Gu, T.; Ma, R.; Yao, W.; Huang, Y.; Gu, J.; Zhao, G. Biochemical characterization of a GH19 chitinase from Streptomyces alfalfae and its applications in crystalline chitin conversion and biocontrol. Int. J. Biol. Macromol. 2021, 167, 193–201. [Google Scholar] [CrossRef]
- Rathore, A.S.; Gupta, R.D. Chitinases from bacteria to human: Properties, applications, and future perspectives. Enzym. Res. 2015, 2015, 791907. [Google Scholar] [CrossRef] [Green Version]
- Bhuiyan, F.A.; Nagata, S.; Ohnishi, K. Novel chitinase genes from metagenomic DNA prepared from marine sediments in southwest Japan. Pak. J. Biol. Sci. 2011, 14, 204–211. [Google Scholar] [CrossRef]
- Jacquiod, S.; Franqueville, L.; Cécillon, S.; Vogel, T.M.; Simonet, P. Soil bacterial community shifts after chitin enrichment: An integrative metagenomic approach. PLoS ONE 2013, 8, e79699. [Google Scholar]
- Cretoiu, M.S.; Berini, F.; Kielak, A.M.; Marinelli, F.; van Elsas, J.D. A novel salt-tolerant chitobiosidase discovered by genetic screening of a metagenomic library derived from chitin-amended agricultural soil. Appl. Microbiol. Biotechnol. 2015, 99, 8199–8215. [Google Scholar] [CrossRef] [Green Version]
- Tamadoni, J.S.; Barzkar, N. Marine bacterial chitinase as sources of energy, eco-friendly agent, and industrial biocatalyst. Int. J. Biol. Macromol. 2018, 120, 2147–2154. [Google Scholar] [CrossRef] [PubMed]
- Yang, S.; Fu, X.; Yan, Q.; Guo, Y.; Liu, Z.; Jiang, Z. Cloning, expression, purification and application of a novel chitinase from a thermophilic marine bacterium Paenibacillus barengoltzii. Food Chem. 2016, 192, 1041–1048. [Google Scholar] [CrossRef]
- Paulsen, S.S.; Andersen, B.; Gram, L.; Machado, H. Biological potential of chitinolytic marine bacteria. Mar. Drugs 2016, 14, 230. [Google Scholar] [CrossRef] [PubMed] [Green Version]
- Take, K.; Fujiki, H.; Suyotha, W.; Hayashi, J.; Takagi, K.; Yano, S.; Wakayama, M. Enzymatic and molecular characterization of an acidic and thermostable chitinase 1 from Streptomyces thermodiastaticus HF 3-3. J. Gen. Appl. Microbiol. 2018, 64, 190–197. [Google Scholar] [CrossRef] [Green Version]
- Gao, L.; Sun, J.; Secundo, F.; Gao, X.; Xue, C.; Mao, X. Cloning, characterization and substrate degradation mode of a novel chitinase from Streptomyces albolongus ATCC 27414. Food Chem. 2018, 261, 329–336. [Google Scholar] [CrossRef] [PubMed]
- He, X.; Yu, M.; Wu, Y.; Ran, L.; Liu, W.; Zhang, X.H. Two highly similar chitinases from marine Vibrio species have different enzymatic properties. Mar. Drugs 2020, 18, 139. [Google Scholar] [CrossRef] [PubMed] [Green Version]
- Shahbaz, U.; Yu, X. Cloning, isolation, and characterization of novel chitinase-producing bacterial strain UM01 (Myxococcus fulvus). J. Genet. Eng. Biotechnol. 2020, 18, 45. [Google Scholar] [CrossRef]
- Kim, S.K.; Kim, Y.H.; Jeong, Y.S.; Na, H.B.; Kim, J.; Baik, K.S.; Yun, H.D.; Lee, J.K.; Kim, H. Chitinibacter suncheonensis sp. nov., a chitinolytic bacterium from a mud flat in Suncheon Bay. J. Microbiol. 2012, 50, 1058–1062. [Google Scholar] [CrossRef] [PubMed]
- Wang, Y.T.; Wu, P.L. Gene cloning, characterization, and molecular simulations of a novel recombinant chitinase from Chitinibacter Tainanensis CT01 appropriate for chitin enzymatic hydrolysis. Polymers 2020, 12, 1648. [Google Scholar] [CrossRef]
- Lin, C.S.; Chen, H.C.; Lin, F.P. Expression and characterization of the recombinant gene encoding chitinase from Aeromonas caviae. Enzyme Microb. Technol. 1997, 21, 472–478. [Google Scholar] [CrossRef]
- Li, Q.; Xiao, X.; Wang, F. Screening of genes involved in chitinase production in Aeromonas caviae CB101 via transposon mutagenesis. J. Appl. Microbiol. 2007, 102, 640–649. [Google Scholar] [CrossRef] [PubMed]
- Mehmood, M.A.; Gai, Y.; Zhuang, Q.; Wang, F.; Xiao, X.; Wang, F. Aeromonas caviae CB101 contains four chitinases encoded by a single gene chi1. Mol. Biotechnol. 2010, 44, 213–220. [Google Scholar] [CrossRef] [PubMed]
- LeCleir, G.R.; Buchan, A.; Maurer, J.; Moran, M.A.; Hollibaugh, J.T. Comparison of chitinolytic enzymes from an alkaline, hypersaline lake and an estuary. Environ. Microbiol. 2007, 9, 197–205. [Google Scholar] [CrossRef] [PubMed]
- Han, Y.; Yang, B.; Zhang, F.; Miao, X.; Li, Z. Characterization of antifungal chitinase from marine Streptomyces sp. DA11 associated with South China Sea sponge Craniella australiensis. Mar. Biotechnol. 2009, 11, 132–140. [Google Scholar] [CrossRef]
- Jankiewicz, U.; Baranowski, B.; Swiontek Brzezinska, M.; Frąk, M. Purification, characterization and cloning of a chitinase from Stenotrophomonas rhizophila G22. 3 Biotech 2020, 10, 16. [Google Scholar] [CrossRef]
- Babashpour, S.; Aminzadeh, S.; Farrokhi, N.; Karkhane, A.; Haghbeen, K. Characterization of a chitinase (Chit62) from Serratia marcescens B4A and its efficacy as a bioshield against plant fungal pathogens. Biochem. Genet. 2012, 50, 722–735. [Google Scholar] [CrossRef] [PubMed]
- Taira, T.; Mahoe, Y.; Kawamoto, N.; Onaga, S.; Iwasaki, H.; Ohnuma, T.; Fukamizo, T. Cloning and characterization of a small family 19 chitinase from moss (Bryum coronatum). Glycobiology 2011, 21, 644–654. [Google Scholar] [CrossRef] [Green Version]
- Yano, S.; Kanno, H.; Tsuhako, H.; Ogasawara, S.; Suyotha, W.; Konno, H.; Makabe, K.; Uechi, K.; Taira, T. Cloning, expression, and characterization of a GH 19-type chitinase with antifungal activity from Lysobacter sp. MK9-1. J. Biosci. Bioeng. 2021, 131, 348–355. [Google Scholar] [CrossRef]
- Honda, Y.; Taniguchi, H.; Kitaoka, M. A reducing-end-acting chitinase from Vibrio proteolyticus belonging to glycoside hydrolase family 19. Appl. Microbiol. Biotechnol. 2008, 78, 627–634. [Google Scholar] [CrossRef]
- Bhattacharya, D.; Nagpure, A.; Gupta, R.K. Bacterial chitinases: Properties and potential. Crit. Rev. Biotechnol. 2007, 27, 21–28. [Google Scholar] [CrossRef]
- Jankiewicz, U.; Brzezinska, M.S.; Saks, E. Identification and characterization of a chitinase of Stenotrophomonas maltophilia, a bacterium that is antagonistic towards fungal phytopathogens. J. Biosci. Bioeng. 2012, 113, 30–35. [Google Scholar] [CrossRef] [PubMed]
- Wang, X.; Chi, N.; Bai, F.; Du, Y.; Zhao, Y.; Yin, H. Characterization of a cold-adapted and salt-tolerant exo-chitinase (ChiC) from Pseudoalteromonas sp. DL-6. Extremophiles 2016, 20, 167–176. [Google Scholar] [CrossRef] [PubMed]
- Tsujibo, H.; Kubota, T.; Yamamoto, M.; Miyamoto, K.; Inamori, Y. Characterization of chitinase genes from an alkaliphilic actinomycete, Nocardiopsis prasina OPC-131. Appl. Environ. Microbiol. 2003, 69, 894–900. [Google Scholar] [CrossRef] [PubMed] [Green Version]
- Tsujibo, H.; Okamoto, T.; Hatano, N.; Miyamoto, K.; Watanabe, T.; Mitsutomi, M.; Inamori, Y. Family 19 chitinases from Streptomyces thermoviolaceus OPC-520: Molecular cloning and characterization. Biosci. Biotechnol. Biochem. 2000, 64, 2445–2453. [Google Scholar] [CrossRef]
- Honda, S.; Kunii, T.; Nohara, K.; Wakita, S.; Sugahara, Y.; Kawakita, M.; Oyama, F.; Sakaguchi, M. Characterization of a Bacillus thuringiensis chitinase that binds to cellulose and chitin. AMB Express 2017, 7, 51. [Google Scholar] [CrossRef] [PubMed] [Green Version]
- Li, J.; Zheng, J.; Liang, Y.; Yan, R.; Xu, X.; Lin, J. Expression and characterization of a chitinase from Serratia marcescens. Protein Expr. Purif. 2020, 171, 105613. [Google Scholar] [CrossRef]
- Gaber, Y.; Mekasha, S.; Vaaje-Kolstad, G.; Eijsink, V.; Fraaije, M.W. Characterization of a chitinase from the cellulolytic actinomycete Thermobifida fusca. Biochim. Biophys. Acta 2016, 1864, 1253–1259. [Google Scholar] [CrossRef] [PubMed]
- Menghiu, G.; Ostafe, V.; Prodanovic, R.; Fischer, R.; Ostafe, R. Biochemical characterization of chitinase A from Bacillus licheniformis DSM8785 expressed in Pichia pastoris KM71H. Protein Expr. Purif. 2019, 154, 25–32. [Google Scholar] [CrossRef] [PubMed] [Green Version]
- Hoster, F.; Schmitz, J.E.; Daniel, R. Enrichment of chitinolytic microorganisms: Isolation and characterization of a chitinase exhibiting antifungal activity against phytopathogenic fungi from a novel Streptomyces strain. Appl. Microbiol. Biotechnol. 2005, 66, 434–442. [Google Scholar] [CrossRef]
- Jankiewicz, U.; Brzezinska, M.S. Purification, characterization, and gene cloning of a chitinase from Stenotrophomonas maltophilia N4. J. Basic Microbiol. 2015, 55, 709–717. [Google Scholar] [CrossRef] [PubMed]
- Malecki, P.H.; Raczynska, J.E.; Vorgias, C.E.; Rypniewski, W. Structure of a complete four-domain chitinase from Moritella marina, a marine psychrophilic bacterium. Acta Crystallogr. D Biol. Crystallogr. 2013, 69, 821–829. [Google Scholar] [CrossRef] [PubMed]
- Hsu, S.C.; Lockwood, J.L. Powdered chitin agar as a selective medium for enumeration of actinomycetes in water and soil. Appl. Microbiol. 1975, 29, 422–426. [Google Scholar] [CrossRef] [PubMed]
- Na, H.B.; Jung, W.K.; Jeong, Y.S.; Kim, H.J.; Kim, S.K.; Kim, J.; Yun, H.D.; Lee, J.K.; Kim, H. Characterization of a GH family 8 β-1,3-1,4-glucanase with distinctive broad substrate specificity from Paenibacillus sp. X4. Biotechnol. Lett. 2015, 37, 643–655. [Google Scholar] [CrossRef] [PubMed]
- Zhang, Z.; Schwartz, S.; Wagner, L.; Miller, W. A greedy algorithm for aligning DNA sequences. J. Comput. Biol. 2000, 7, 203–214. [Google Scholar] [CrossRef] [PubMed]
- Morgulis, A.; Coulouris, G.; Raytselis, Y.; Madden, T.L.; Agarwala, R.; Schäffer, A.A. Database indexing for production MegaBLAST searches. Bioinformatics 2008, 24, 1757–1764. [Google Scholar] [CrossRef] [PubMed]
- Almagro Armenteros, J.J.; Tsirigos, K.D.; Sønderby, C.K.; Petersen, T.N.; Winther, O.; Brunak, S.; von Heijne, G.; Nielsen, H. SignalP 5.0 improves signal peptide predictions using deep neural networks. Nat. Biotechnol. 2019, 37, 420–423. [Google Scholar] [CrossRef]
- Miller, G.L. Use of dinitrosalicylic acid reagent for the determination of reducing sugar. Anal. Chem. 1959, 31, 428–436. [Google Scholar] [CrossRef]
- Oh, J.M.; Lee, J.P.; Baek, S.C.; Kim, S.G.; Jo, Y.D.; Kim, J.; Kim, H. Characterization of two extracellular β-glucosidases produced from the cellulolytic fungus Aspergillus sp. YDJ216 and their potential applications for the hydrolysis of flavone glycosides. Int. J. Biol. Macromol. 2018, 111, 595–603. [Google Scholar] [CrossRef]
- Bradford, M.M. A rapid and sensitive method for the quantitation of microgram quantities of protein utilizing the principle of protein-dye binding. Anal. Biochem. 1976, 72, 248–254. [Google Scholar] [CrossRef]
- Laemmli, U.K. Cleavage of structural proteins during the assembly of the head of bacteriophage T4. Nature 1970, 227, 680–685. [Google Scholar] [CrossRef] [PubMed]
- Xia, G.; Jin, C.; Zhou, J.; Yang, S.; Zhang, S.; Jin, C. A novel chitinase having a unique mode of action from Aspergillus fumigatus YJ-407. Eur. J. Biochem. 2001, 268, 4079–4085. [Google Scholar] [CrossRef] [PubMed]

| Primer Name | Primer Sequence | ||
|---|---|---|---|
| ORF(1) F | 5′ | GAAACCAGGAATTCGTCCGAATTTTAATCG | 3′ |
| ORF(1) R | 5′ | TGGCTCTGGGCAAACTGG | 3′ |
| ORF(2) F | 5′ | CGGTGCAGGACAAGGTCT | 3′ |
| ORF(2) R | 5′ | AGCCCCTCCACCAGCTTGA | 3′ |
| ORF(3) F | 5′ | AGCAGATCACCGTCTCGC | 3′ |
| ORF(3) R | 5′ | TCAGCTGCGCTGCCAGTTCAGCATG | 3′ |
| ORF(1+2) F | 5′ | GAAACCAGGAATTCGTCCGAATTTTAATCG | 3′ |
| ORF(1+2) R | 5′ | AGCCCCTCCACCAGCTTGA | 3′ |
| ORF(2+3) F | 5′ | CGGTGCAGGACAAGGTCT | 3′ |
| ORF(2+3) R | 5′ | TCAGCTGCGCTGCCAGTTCAGCATG | 3′ |
| ORF(1+2+3) F | 5′ | GAAACCAGGAATTCGTCCGAATTTTAATCG | 3′ |
| ORF(1+2+3) R | 5′ | TCAGCTGCGCTGCCAGTTCAGCATG | 3′ |
| Family 18 | ||||||||||||||||
|---|---|---|---|---|---|---|---|---|---|---|---|---|---|---|---|---|
| Protein | Accession | Source | Homology (%) * | AA | MW (kDa) | Opt. Temp. (°C) | Opt. pH | Ion Effects | Major Product | ChBD ** | Type of Reaction | Ref. | ||||
| A | C | D | Activating | Inhibiting | ||||||||||||
| Chi18A | MZ673655 | Aeromonas sp. SK10 | 80 | 13 | 869 | 92.7 | 50 | 8.0 | Mg2+, K+ | Cu2+, Fe3+, Mn2+ | O | Endo | This study | |||
| Chi18C | MZ673657 | Aeromonas sp. SK15 | 80 | 12 | 865 | 91.6 | 60 | 7.0–8.0 | Cu2+, Mn2+, Ca2+ | Ch2 | O | Endo | ||||
| Chi18D | MZ673658 | Chitinibacter suncheonensis sp. nov. SK16 | 13 | 12 | 664 | 70.8 | 50 | 9.0–10.0 | Mn2+ | Cu2+ | Ch2 | O | Endo | |||
| SaChiA4 | AXY65110 | Streptomyces albolongus ATCC 27414 | 9 | 4 | 4 | 427 | 44.7 | 50 | 5.0 | Mn2+ | Cu2+, Fe3+ | Ch2 | Endo | [15] | ||
| UMCda | QJX74482 | Myxococcus fulvus UM01 | 3 | 4 | 6 | 234 | 26.1 | 35 | 7.0 | Endo | [17] | |||||
| ChiC | ABY83190 | Streptomyces sp. DA11 | 6 | 4 | 4 | 148 | 16.4 | 50 | 8.0 | Mn2+, Cu2+, Mg2+ | Fe2+, Ba2+ | Endo | [24] | |||
| G22 | BBN21352 | Stenotrophomonas rhizophila G22 | 12 | 12 | 32 | 702 | 72.6 | 37 | 5.9 | Mn2+, Ca2+ | Cu2+, Fe2+ | Ch2 | O | Endo | [25] | |
| Chit62 | ADR30609 | Serratia marcescens | 48 | 37 | 12 | 566 | 61.4 | 55 | 6.0 | [26] | ||||||
| MUJ | AAB70917 | Stenotrophomonas maltophilia | 11 | 13 | 20 | 700 | 72.3 | 45 | 6.8 | Ca2+, Mg2+ | Hg2+, Cu2+, Zn2+ | O | [31] | |||
| ChiC | AGU01018 | Pseudomonas sp. DL-6 | 43 | 34 | 12 | 876 | 92.7 | 30 | 9.0 | Na+, K+, Ca2+ | Fe3+, Zn2+, Cu2+ | Ch2 | X | Exo | [32] | |
| ChiA | BAC45251 | Nocardiopsis prasine OPC-131 | 7 | 4 | 4 | 336 | 35.2 | 60 | 7 | X | Endo | [33] | ||||
| BthChi74 | BAW98208 | Bacillus thuringiensis | 19 | 13 | 13 | 676 | 74.4 | 55 | 4.0–6.0 | Ch2 | O | Exo | [35] | |||
| rCHI-2 | QIM58707 | Serratia marcescens | 11 | 9 | 9 | 499 | 55.6 | 55 | 6.0 | Cr2+, K+, Pb2+ | Ag+, Cu2+ | Ch2 | Endo | [36] | ||
| Tf Chi18A | Q47RL1 | Thermobifida fusca YX | 13 | 10 | 13 | 451 | 50.6 | 40–45 | 6.5 | Ch2 | O | Endo | [37] | |||
| ChiA | ACK44109 | Bacillus licheniformis DSM8785 | 20 | 13 | 12 | 580 | 64.0 | 50–60 | 4.0–5.0 | Ch2 | Endo | [38] | ||||
| Sm4 | BAP19085 | Stenotrophomonas maltophilia | 12 | 13 | 21 | 701 | 73.0 | 45 | 5.6 | Hg2+ | Endo | [40] | ||||
| Family 19 | ||||||||||||||||
| Protein | Accession | Source | Homology (%) | AA | MW (kDa) | Opt. Temp. (°C) | Opt. pH | Ion Effects | Major Product | ChBD ** | Type of Reaction | Ref. | ||||
| Activating | Inhibiting | |||||||||||||||
| Chi19B | MZ673656 | Aeromonas sp. SK10 | 659 | 70.6 | 50 | 9.0 | Mn2+, Mg2+, K+ | Zn2+, Cu2+, Fe3+ | X | Exo | This study | |||||
| BcChiA | BAF99002 | Bryum coronatum | 10.4 | 228 | 24.8 | X | Endo | [27] | ||||||||
| Chi19MK | BCJ03976 | Lysobacter sp. MK9-1 | 11.3 | 311 | 33.7 | Ch2 | O | [28] | ||||||||
| Chi19 | BAE86996 | Vibrio proteolyticus | 31.0 | 544 | 60.1 | 40 | 5.5–7.0 | Ch2 | O | Exo-like | [29] | |||||
| ChiB | BAC45252 | Nocardiopsis prasine OPC-131 | 11.6 | 296 | 31.5 | 60 | 6.0 | O | [33] | |||||||
| Chi35 | BAA88833 | Streptomyces thermoviolaceus | 12.3 | 377 | 39.8 | 60 | 5–6 | O | [34] | |||||||
| Chi25 | BAA88834 | 11.1 | 269 | 28.7 | 70 | 5–6 | X | |||||||||
| ChiIS | AAT27430 | Streptomyces sp. MG3 | 11.4 | 303 | 31.8 | 50 | 5–7 | O | [39] | |||||||
| Primer Name | Primer Sequence | mer | ||
|---|---|---|---|---|
| Chi18A F | 5′ | ATATCGACTGGGCATTCCCGGGTGG | 3′ | 25 |
| Chi18A R | 5′ | CCACCCGGGAATGCCCAGTCGATAT | 3′ | 25 |
| Chi18C F | 5′ | ACATCGACTGGGCGTTCCCGGGCGGA | 3′ | 26 |
| Chi18C R | 5′ | TCCGCCCGGGAACGCCCAGTCGATGT | 3′ | 26 |
| Chi18D F | 5′ | GATATCGATTGGGCATTCCCAGGTGTT | 3′ | 27 |
| Chi18D R | 5′ | AACACCTGGGAATGCCCAATCGATATC | 3′ | 27 |
| Primer Name | Primer Sequence | mer | ||
|---|---|---|---|---|
| Chi18C F | 5′ | TTTGAATTCATGTTAAGTCCAAAACTTTCC | 3′ | 30 |
| Chi18C R | 5′ | TTTAAGCTTTCAGTTGCAGCTCGCC | 3′ | 25 |
| Chi18D F | 5′ | TTTGGATCCATGAGGATGGAGACCCTTATG | 3′ | 30 |
| Chi18D R | 5′ | TTTGAGCTCTTGACGAGCTTTACCCATTC | 3′ | 29 |
Publisher’s Note: MDPI stays neutral with regard to jurisdictional claims in published maps and institutional affiliations. |
© 2021 by the authors. Licensee MDPI, Basel, Switzerland. This article is an open access article distributed under the terms and conditions of the Creative Commons Attribution (CC BY) license (https://creativecommons.org/licenses/by/4.0/).
Share and Cite
Kim, S.K.; Park, J.E.; Oh, J.M.; Kim, H. Molecular Characterization of Four Alkaline Chitinases from Three Chitinolytic Bacteria Isolated from a Mudflat. Int. J. Mol. Sci. 2021, 22, 12822. https://doi.org/10.3390/ijms222312822
Kim SK, Park JE, Oh JM, Kim H. Molecular Characterization of Four Alkaline Chitinases from Three Chitinolytic Bacteria Isolated from a Mudflat. International Journal of Molecular Sciences. 2021; 22(23):12822. https://doi.org/10.3390/ijms222312822
Chicago/Turabian StyleKim, Sung Kyum, Jong Eun Park, Jong Min Oh, and Hoon Kim. 2021. "Molecular Characterization of Four Alkaline Chitinases from Three Chitinolytic Bacteria Isolated from a Mudflat" International Journal of Molecular Sciences 22, no. 23: 12822. https://doi.org/10.3390/ijms222312822
APA StyleKim, S. K., Park, J. E., Oh, J. M., & Kim, H. (2021). Molecular Characterization of Four Alkaline Chitinases from Three Chitinolytic Bacteria Isolated from a Mudflat. International Journal of Molecular Sciences, 22(23), 12822. https://doi.org/10.3390/ijms222312822

